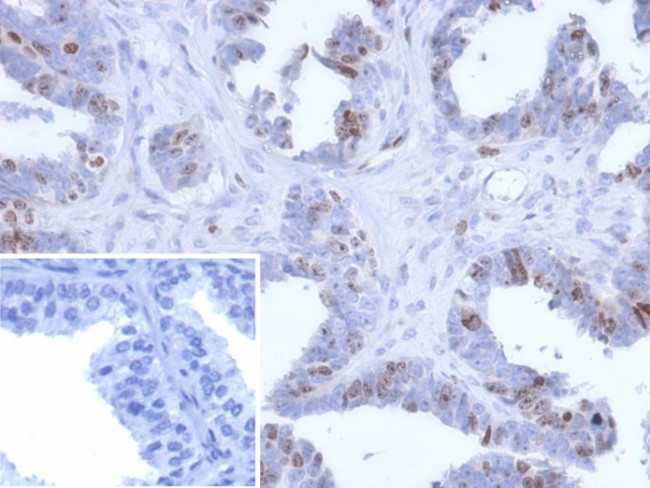
BATF2/SARI (Transcription Factor) Antibody in Immunohistochemistry (Paraffin) (IHC (P))

Search
NeoBiotechnologies
BATF2/SARI (Transcription Factor) Monoclonal Antibody (PCRP-BATF2-2B9)
{{$productOrderCtrl.translations['antibody.pdp.commerceCard.promotion.promotions']}}
{{$productOrderCtrl.translations['antibody.pdp.commerceCard.promotion.viewpromo']}}
{{$productOrderCtrl.translations['antibody.pdp.commerceCard.promotion.promocode']}}: {{promo.promoCode}} {{promo.promoTitle}} {{promo.promoDescription}}. {{$productOrderCtrl.translations['antibody.pdp.commerceCard.promotion.learnmore']}}




Please note: We are reviewing Western blot images included in the antibody testing data in our catalog, including those provided by third parties. Unless expressly labeled or annotated as “raw-unedited”, Western blot images included in the antibody testing data in our catalog may have been edited, optimized or otherwise adjusted for presentation.
产品信息
116071-MSM2-P0
种属反应
宿主/亚型
分类
类型
克隆号
抗原
偶联物
形式
浓度
规格
纯化类型
保存液
内含物
保存条件
运输条件
靶标信息
BATF2 (basic leucine zipper transcription factor, ATF-like 2) is a 274 amino acid protein that localizes to the nucleus and contains one bZIP domain, suggesting that it may be involved in transcriptional regulation. The gene encoding BATF2, which is expressed as multiple alternatively spliced isoforms, is located on human chromosome 11. With approximately 135 million base pairs and 1, 400 genes, chromosome 11 comprises approximately 4% of human genomic DNA and is considered a gene and disease association dense chromosome. The chromosome 11 encoded Atm gene is important for regulation of cell cycle arrest and apoptosis following double strand DNA breaks. Atm mutation leads to the disorder known as ataxia-telangiectasia. The blood disorders Sickle cell anemia and thalassemia are caused by HBB gene mutations, while Wilms' tumors, WAGR syndrome and Denys-Drash syndrome are associated with mutations of the WT1 gene. Jervell and Lange-Nielsen syndrome, Jacobsen syndrome, Niemann-Pick disease, hereditary angioedema and Smith-Lemli-Opitz syndrome are also associated with defects in chromosome 11-encoded genes.
仅用于科研。不用于诊断过程。未经明确授权不得转售。
篇参考文献 (0)
生物信息学
蛋白别名: B-ATF-2; Basic leucine zipper transcriptional factor ATF-like 2; MGC20410; SARI; Suppressor of AP-1 regulated by IFN
基因别名: BATF2
Entrez Gene ID: (Human) 116071